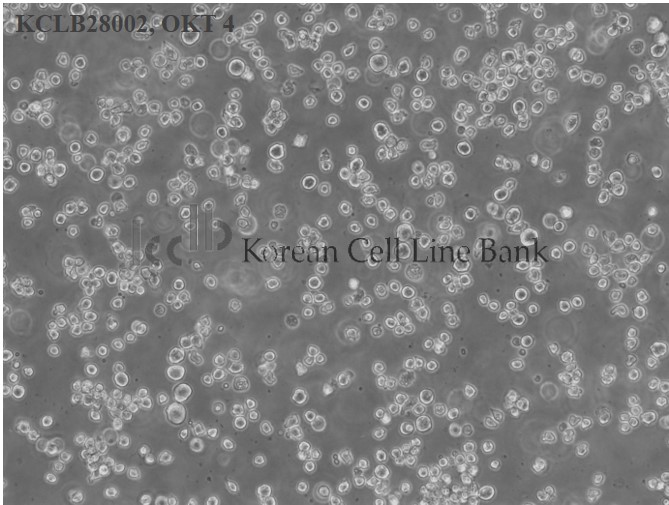
OKT 4

OKT 4
| KCLB NO |
28002
|
|---|---|
| Name |
OKT 4
|
세포주 분양조건
서비스
수량
-
+
| Origin |
hybridoma
|
|---|---|
| Species |
mouse
|
| Cellular morphology |
lymphoblast-like
|
| Production |
anti human helper cell subset
|
| Growth Pattern |
suspension
|

준비중입니다.
| freeze media |
RPMI1640, 52.5%; FBS, 40%; DMSO, 7.5%
|
|---|---|
| original medium |
RPMI1640 with L-glutamine (300mg/L), 25mM HEPES and 25mM NaHCO3, 90%; heat inactivated fetal bovine serum (FBS), 10%
|
| kclb media |
Dulbecco's modified Eagle's medium, 90%; heat inactivated fetal bovine serum (FBS) 10%
|


